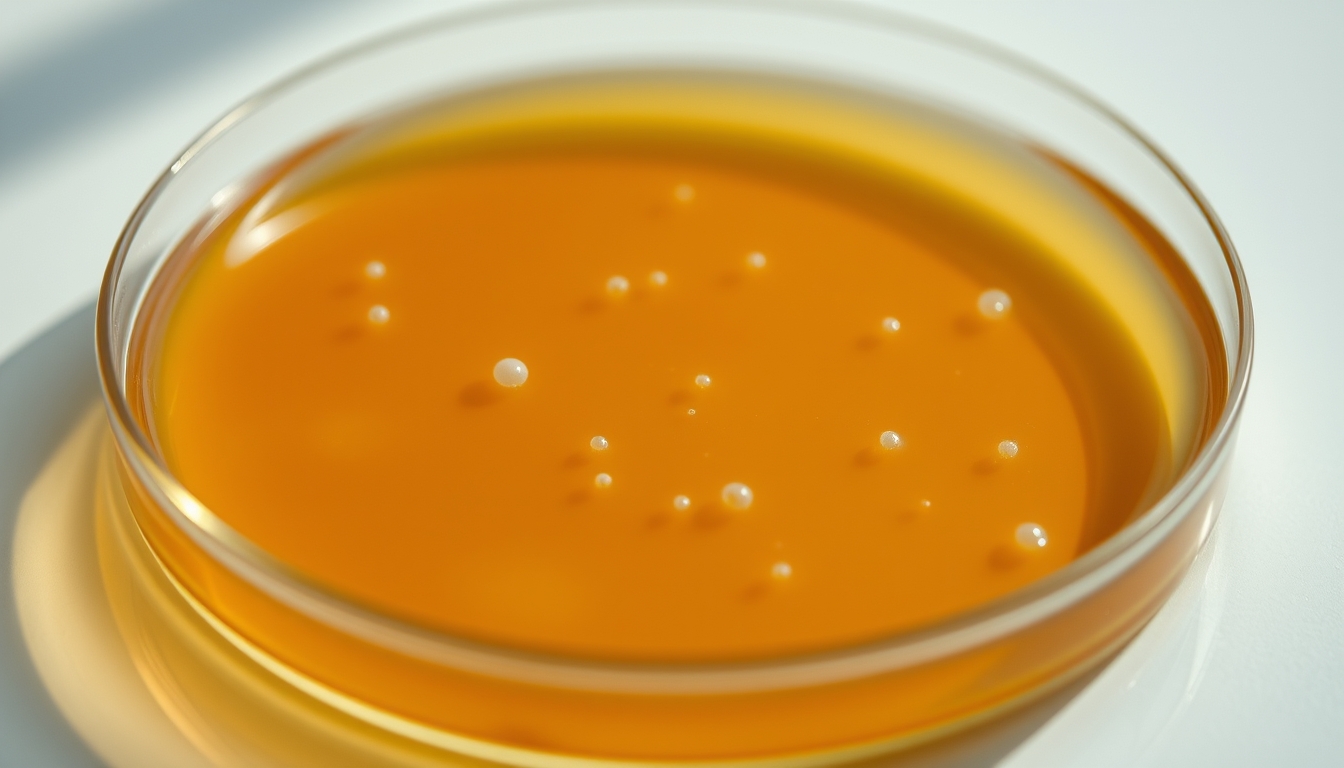
bacterial colony petri dish in editorial style

Brazilian image library, free with attribution
High-quality stock photos about Brazil. AI-curated for editorial use, business, blogs and presentations.

Fusion reactor tokamak
physics1344×768
Photon wave particle
physics1344×768
Nuclear reactor core glow
physics1344×768
Bubble chamber tracks
physics1344×768
Periodic table elements glow
physics1344×768
Particle accelerator interior cern
physics1344×768
Quantum entanglement visualization
physics1344×768
Atom 3d render electron orbit
physics1344×768
Clinical trial vials
biology1344×768
Pharmaceutical research lab
biology1344×768
Biomedical lab clean
biology1344×768
Tissue culture biology lab
biology1344×768
Electron microscope sample
biology1344×768
Cell sorting facs machine
biology1344×768
Crispr gene editing concept
biology1344×768
Pcr machine running cycle
biology1344×768
Gene therapy concept render
biology1344×768
Organ on chip device
General1344×768
Enzyme catalysis 3d
biology1344×768
Photosynthesis chloroplast
General1344×768
Mrna vaccine vial closeup
biology1344×768
Stem cells petri dish
biology1344×768
Plant cell wall closeup
biology1344×768
Antibody structure render
biology1344×768
White blood cells macro
biology1344×768
Osmosis membrane diagram
General1344×768
Ribosome detail render
biology1344×768
Red blood cells flowing
biology1344×768
Nucleus chromosomes microscope
biology1344×768
Virus 3d render covid
biology1344×768
Protein structure 3d
biology1344×768
Bacterial colony petri dish
biology1344×768
Amethyst geode purple
minerals1344×768
Rna molecule structure
biology1344×768
Mitochondria 3d render
biology1344×768
Dna helix glowing blue
biology1344×768
Cell division microscope
biology1344×768
Olive grove sunset golden
Agriculture1344×768
Olive tree blossoms spring
Agriculture1344×768
Quantum computer chip
physics1344×768
Cold pressed olive oil drops
Agriculture1344×768
Olive oil tasting glasses
Agriculture1344×768
Olives in clay jar
Agriculture1344×768
Olive leaf macro detail
Agriculture1344×768
Centenary olive tree spain
Agriculture1344×768
Olive grove tuscany hillside
Agriculture1344×768
Olive press traditional stone
Agriculture1344×768
Olive oil pouring from bottle
Agriculture1344×768
Olive harvest baskets
Agriculture1344×768
Ruby red gemstone
minerals1344×768
Olive branches with green olives
Agriculture1344×768
Mediterranean olive plantation aerial
Agriculture1344×768
Extra virgin olive oil bottle
Agriculture1344×768
Ancient olive tree gnarled trunk
Agriculture1344×768
Sapphire blue gemstone
minerals1344×768
Diamond rough crystal
minerals1344×768
Aquamarine pale blue
minerals1344×768
Emerald rough green
minerals1344×768
Tanzanite blue purple
minerals1344×768
Turquoise polished
minerals1344×768
Popular tags
- global 980
- unique-2500 540
- trending-2026 254
- anomaly-detected 153
- travel 143
- magazine-editorial 121
- commercial-product-photography 96
- fine-art-photography 89
- minimalist-composition 83
- aerial-drone-shot 70
- nature 70
- cinematic-wide-shot 69
- macro-closeup 66
- lifestyle 63
- documentary-photography 61
- food 57
- cripto 52
- business 47
- studio-editorial-portrait 41
- saude 41
License: free with attribution
All images are licensed under Creative Commons Attribution 4.0 (CC-BY 4.0). You can use them in commercial and non-commercial projects, just credit "UtilizAí" with a link back to xn--utiliza-eza.com.